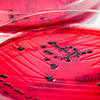

November 2019 Newsletter

Gregor Reid and his team are using probiotics to protect honey bees
Faculty and trainees shared their expertise in insect biology and beneficial microbes to study how a probiotic BioPatty can protect honey bees from fatal disease. "We observed an increase in pathogen clearance and overall survival of honey bee larvae," said PhD Candidate Brendan Daisley.
 Bringing infection to its knees
Bringing infection to its knees
PhD Candidate Adam Paish is part of a team of basic scientists and clinicians across the School that is working to reduce infection rates for millions of people undergoing orthopaedic surgery. Solving a genetic puzzle
Solving a genetic puzzle
Triplets in their late 70s. Identical DNA. Two develop Alzheimer’s disease and one does not. PhD Candidate Allison Dilliott is part of a research team investigating this challenging genetic puzzle. Celebrating science, discovery and the next generation
Celebrating science, discovery and the next generation
Trainees were a big focus of Robarts Research Institute’s Celebration of Science and Discovery this week, as they joined faculty in showcasing research projects for community members and participating in the annual Taylor Symposium. CRISPR research makes international headlines
CRISPR research makes international headlines
“CRISPR is the next step in antimicrobial therapy,” says David Edgell, PhD. He led a recent study that was published in Nature Communications and featured in The New York Times. Researchers honoured for innovation milestones
Researchers honoured for innovation milestones
Several of your colleagues were recognized at this year’s WORLDiscoveries Vanguard Awards for their business and commercialization successes. Award-winning projects from the Summer Research Training Program
Award-winning projects from the Summer Research Training Program
Congratulations to recipients of the 2019 SRTP Awards and their supervisors. Projects focused on head and neck cancer, cardiac rehabilitation, paediatric neuromuscular diseases and medical education. Inspiring the future of cancer research
Inspiring the future of cancer research
Claire Park, PhD Candidate, is developing an image-guided biopsy system to better detect and diagnose breast cancer. Community-driven approach to research leads to solutions for diabetes care
Community-driven approach to research leads to solutions for diabetes care
The FORGE AHEAD project empowered Indigenous communities across the country to take a leading role in addressing Type 2 diabetes. Collaborative Research Seed Grants – Apply by December 18
Collaborative Research Seed Grants – Apply by December 18
The CRSG program provides seed funding for new interdisciplinary, collaborative research teams.- Celebrating your recent achievements
Congratulations to Ruth Lanius, Vivian McAlister and Kara Ruicci, as well as many others, on your recent accomplishments. - Featured publications
This month we are featuring recent publications from Anesthesia and Perioperative Medicine. - Events
Upcoming events include a workshop on altmetrics (November 20), the History of Medicine Visiting Speaker Annual Lecture (November 21) and Parkwood Institute’s Research Open House (November 28).


